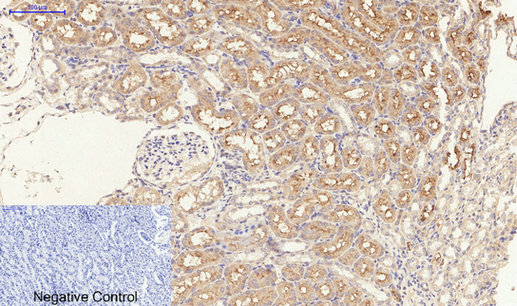

Anti-TGF beta Receptor I (phospho Ser165) Antibody
A94342
ApplicationsImmunoFluorescence, ELISA
Product group Antibodies
ReactivityHuman, Mouse, Rat
Overview
- SupplierAntibodies.com
- Product NameAnti-TGF beta Receptor I (phospho Ser165) Antibody
- Delivery Days Customer7
- Antibody SpecificityThis antibody detects endogenous levels of TGF beta Receptor I only when phosphorylated at Ser165.
- ApplicationsImmunoFluorescence, ELISA
- CertificationResearch Use Only
- ClonalityPolyclonal
- ConjugateUnconjugated
- HostRabbit
- IsotypeIgG
- Scientific DescriptionRabbit polyclonal antibody to TGF beta Receptor I (phospho Ser165).
- ReactivityHuman, Mouse, Rat
- UNSPSC12352203